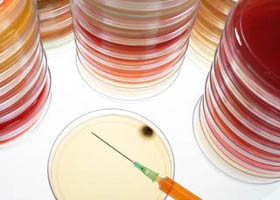
Echinococcosis

Az echinococcosis (ejtsd: ehinokokkózis) parazitás fertőző betegség. Két fő típusa van a betegségnek: a cisztás echinococcosis és az alveolaris echinococcosis.
1. Mi az echinococcosis?
Echinococcosis
Forrás: Országos Epidemiológiai Központ, OTH Járványügyi Főosztály
Az echinococcosis (ejtsd: ehinokokkózis) parazitás fertőző betegség. Két fő típusa van a betegségnek: a cisztás echinococcosis és az alveolaris echinococcosis. Az előbbit az Echinococcus granulosus, az utóbbit az Echinococcus multilocularis nevű galandféreg lárvái okozzák.
2. Milyen az Echinococcus fejlődési folyamata?
Az Echinococcus granulosus galandféreg felnőtt, ivarérett formája a vadon élő és a házi kutyafélék belében élősködik. A féreg petéi a kutyák ürülékével kerülnek a szabadba. A féregpetékkel szennyezett növényeket elfogyasztják a növényevő állatok (pl. a juh, szarvasmarha, kecske, ló), a sertés, olykor pedig az ember is. Az elfogyasztott petékből az állatok és az ember belében lárvák fejlődnek ki. A lárvák a bélfalon át a vérkeringésbe, onnan a májba (néha a tüdőbe, vagy egyéb szervekbe) jutnak. Ott megtelepszenek, folyadékot tartalmazó tömlők (= ciszták) fejlődnek ki belőlük, ezek növekednek, károsítják a szöveteket, szerveket és betegségtüneteket okoznak. A másik galandféreg, az Echinococcus multilocularis fejlődésmenete ehhez hasonló, de itt a felnőtt galandférgek általában a rókák belében élősködnek, a peték a rókák ürülékével jutnak a szabadba, onnan a kisrágcsálókba (pl. egér, cickány), ritkán az emberbe is, s bennük fejlődnek ki a lárvák. A körfolyamat úgy lesz teljes, hogy a kutya félék a lárvákkal fertőzött állatok szerveit (máját!), a rókák pedig a fertőzött kisrágcsálókat elfogyasztják, s beleikben kialakulnak a felnőtt galandférgek. Ezzel újra kezdődik a körfolyamat.
3. Hol fordul elő az echinococcosis? Hogyan terjed?
A cisztás echinococcosis gyakorlatilag az egész világon, így Magyarországon is előfordul. Leggyakoribb azokban az országokban, ahol intenzív juhtenyésztés folyik. Az alveoláris echinococcosis ritkább (de súlyosabb) betegség, mint a cisztás echinococcosis. Emberi alveoláris echinococcosist, Magyarországon eddig még nem diagnosztizáltak, de a környező államokban igen. így várható, hogy hazánkban is megjelenik. Az Echinococcus peték a kutyák, illetve a rókák ürülékével a szabadba jutva azonnal fertőzőképesek. Legalább egy évig életben maradnak a külvilágban, ezalatt szétszóródnak. A szél és a legyek is elősegítik a terjedésüket. A kutyák székletürítési helyei mindenki, de különösen a gyermekek számára erős fertőzési veszélyt jelentenek. A petékkel szennyezett földön termő élelmiszerek (erdei szamóca, földi eper, saláta), de a szennyezett víz is fertőzés forrása lehet. Az átlagosnál veszélyeztetettebbek a gyermekek, a kutyatartók (és családtagjaik), illetve a rókavadászok.
4. Mik az echinococcosis tünetei?
Az echinococcosis fertőzés kezdeti szakasza általában tünetmentes. Rendszerint évek múlva jelentkeznek a panaszok: májtáji fájdalom (a has felső részében), májmegnagyobbodás, étvágytalanság, majd sárgaság jelentkezhet. A tüdőben levő ciszta köhögést okozhat.
5. Hogyan diagnosztizálják az echinococcosist?
A beteg panaszainak és a klinikai tüneteknek az értékelésén túl fontos Rtg, UH és CT vizsgálat végzése. Ezt immunológiai laboratóriumi vizsgálatokkal egészítik ki, amikor is a vérből a parazita testanyagaival szemben termelődött ellenanyagokat mutatják ki. A korai diagnózisnak igen nagy a jelentősége az eredményes kezelés szempontjából.
6. Hogyan kezelik az echinococcosist?
Alapvető kezelési mód az Echinococcus ciszta sebészi eltávolítása. Ez teljes és végleges gyógyulást eredményezhet. Minél kevesebb és minél kisebb ciszta van, annál egyszerűbb és hatékonyabb a sebészi beavatkozás. A másik fontos kezelési mód lényege az, hogy vékony tűvel megcsapolják a cisztát, majd a leszívott folyadék helyére a lárvákat károsító folyadékot fecskendeznek be, végül ezt is leszívják. A kezelést többször megismétlik. Harmadik kezelési mód az Echinococcus-elleni gyógyszerek adagolása. Legtöbbször az albendazol és a mebendazol nevű szert alkalmazzák, a sebészeti kezelés kiegészítésére, de a nem operálható esetekben is. A gyógyszeres kezelés hónapokig, évekig, olykor az élet végéig tart.
7. Hogyan védekezzünk az echinococcosis ellen?
Nagyon fontos a kutyák rendszeresen (6 hetente) történő kezelése Echinococcus elleni szerrel (praziquantel), mivel az Echinococcus 5-7 hét alatt válik ivaréretté. Kritikus pont a kóbor kutyák ellenőrzése, de éppen így a sertésvágások tisztaságának fenntartása is. A kutyák ne fogyaszthassanak vágóhídi belsőségeket nyersen. Kerülni kell az ápolatlan szőrzetű kutyákkal a közvetlen kapcsolatot, különösen a gyermekeknek, mert a peték a kutyaszőrhöz is hozzátapadhatnak. Sétáltatáskor tartsuk pórázon kedvenceinket, s ne feledjük, hogy minden kutyatulajdonosnak kötelessége az ürülék eltakarítása a közterületen. Gyermekeknek különösen a kutya-ürülékkel szennyezett homokozók veszélyesek. A rendszeres, gyakori kézmosás egyszerű, de hatékony óvórendszabály. Szoktassuk rá a gyermekeket, különösen kutyával való játszadozás után. Az étkezés előtti kézmosás egyébként mindenkinek kutyakötelessége. Nyers gyümölcsöt, nyers zöldséget csak gondos mosás után fogyasszunk. Ne igyunk vizet patakból, forrásból, mert kutya-róka ürülékkel szennyezett lehet. Ne feledjük, hogy orvosunk, állatorvosunk tanácsára és segítségére mindenkor számíthatunk.
Echinococcus vizsgálatokat végez:
a Johan Béla Országos Epidemiológiai Központ, Parazitológiai Osztályának
Zoonótikus Fertőzések Nemzeti Referencia Laboratóriuma
A tájékoztató internetről letölthető
Járványokkal, fertőző betegségekkel és megelőzésükkel kapcsolatosan további aktuális információkat talál:
az OTH honlapján (www.antsz.hu)
az OEK járványügyi tájékoztatást adó zöld számon: 06-80-204-217 valamint
e-mail-en: jarvanyinfo@oek.antsz.hu
A tájékozatók célja, hogy széles körben ismertessék a fertőző betegségek megelőzésének, leküzdésének lehetőségeit.
Kövesse az Egészségkalauz cikkeit a Google Hírek-ben, a Facebook-on, az Instagramon vagy a X-en,Tiktok-on is!








